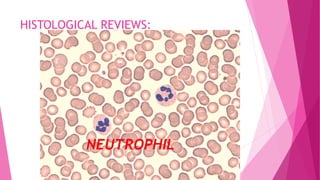
HISTOLOGICAL REVIEWS:
NEUTROPHIL
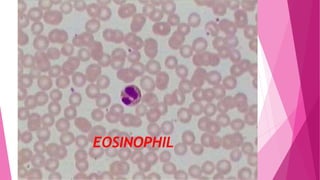
EOSINOPHIL
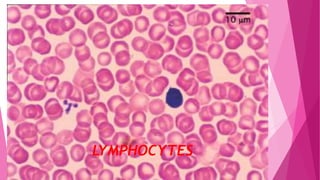
LYMPHOCYTES
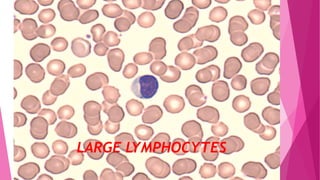
LARGE LYMPHOCYTES

This document provides an overview of white blood cells (WBCs), also known as leukocytes. It discusses the discovery of WBCs, the types of WBCs including granulocytes and agranulocytes, the formation and development of WBCs through hematopoiesis and leukopoiesis, the morphology and functions of different WBC types such as neutrophils, eosinophils, basophils, lymphocytes and monocytes. It also addresses the regulation of leukopoiesis, metabolism of WBCs, normal WBC counts and percentages, and the kinetics and lifespan of neutrophils.
![DR.A.BEEULA
1ST MDS
DEPT.OF ORAL PATHOLOGY
CHETTINAD DENTAL COLLEGE AND RI
WHITE BLOOD
CELLS [WBC]](https://image.slidesharecdn.com/whitebloodcellswbc-180530054405/85/White-blood-cells-wbc-1-320.jpg)



![LEUKOCYTES:[WBC’S]
MOBILE UNITS OF BODY’S DEFENSE SYSTEM:
“SEEK AND DESTROY”FUNCTION:
DESTROY INVADING MICRO ORGANISM
DESTROY ABNORMAL CELLS(I.E.:CANCER)
CLEAN UP CELLULAR DEBRIS{PHAGOCYTOSIS}
ASSIST IN INJURY REPAIR
EACH WBC HAS A SPECIFIC FUNCTION](https://image.slidesharecdn.com/whitebloodcellswbc-180530054405/85/White-blood-cells-wbc-5-320.jpg)



![GRANULES:
CYTOPLASM CONTAINS TWO MAIN TYPES OF GRANULES:
LESS NUMEROUS,LARGE, MOST NUMEROUS TYPE,SMALL WITH
REDDISH PURPLE PINKISH HUE[NUTRAL STAINING]
CONTAINS:MYELOPER OXIDASE/ SO,NOT EASILY SEEN
ACID HYDROLASES
AZUROPHILIC
[PRIMARY]
GRANULES
SECONDARY/SPECIFIC
GRANILES](https://image.slidesharecdn.com/whitebloodcellswbc-180530054405/85/White-blood-cells-wbc-9-320.jpg)


![NORMAL WBC COUNT:
TOTAL LEUCOCYTE COUNT[TLC]
ADULTS: 4000-11,000/MM3 OF BLOOD
AT BIRTH: 10,000-25,000/MM3 OF BLOOD
INFANTS UPTO 1 YR OF AGE: 6,000-16,000/MM3
OF BLOOD
CHILDRENS: 4-7 YRS OF AGE: 5,000-
15,000/MM3 OF BLOOD
CHILDREN:8-12 YRS: 4,500-13,500/MM3 OF
BLOOD](https://image.slidesharecdn.com/whitebloodcellswbc-180530054405/85/White-blood-cells-wbc-12-320.jpg)


![FORMATION OF WBC:
THE PROCESS OF DEVELOPMENT AND MATURATION OF
WHITE BLOOD CELLS(LEUCOCYTES) CALLED
LEUCOPOIESIS.,IS A PART OF HAEMOPOIESIS(FORMATION OF
BLOOD CELLS)
ALL BLOOD CELLS-DEVELOP FROM PLURIPOTENT
HAEMOPOITIC STEM CELLS[PHSC’S]
LEUCOPOIESIS:
* FORMATION OF
GRANULOCYTES[GRANULOPOIESIS]AND MONOCYTES
* FORMATION OF LYMPHOCYTES[LYMPHOPOIESIS]](https://image.slidesharecdn.com/whitebloodcellswbc-180530054405/85/White-blood-cells-wbc-15-320.jpg)
![FORMATION OF GRANULOCYTES AND
MONOCYTES:
GRANULOCYTES AND MONOCYTES ARE FORMED
FROM BONE MARROW,WHICH IS DERIVED FROM
CFU-GM(COLONY FORMING UNITS OF
GRANULOCTYES AND MONOCYTES)
THE PROGENITOR CELLS[CFU-GM] FORMING
DIFFERENT CELLS ARE FURTHER NAMED AS;
CFU-G=NEUTROPHIL FORMING UNITS
CFU-E=EOSINOPHIL FORMING UNITS
CFU-B-BASOPHIL FORMING UNITS
CFU-M=MONOCYTE FORMING UNITS](https://image.slidesharecdn.com/whitebloodcellswbc-180530054405/85/White-blood-cells-wbc-16-320.jpg)


![MYELOBLAST:
IT IS THE EARLIEST RECOGNIZABLE CELL OF THE
GRANULOCYTE SERIES:
SIZE:16-20uM
CYTOPLASM: BASOPHILIC
PRESENT AS THIN RIM AROUND THE
NUCLEAUS
DEVOID OF GRANULES
NUCLEUS: LARGE NEARLY FILLING THE CELLS
ROUND TO OVAL
FINE CHROMATIN
2-5 WELL DEFINED PALE NUCLEOLI
MITOSIS: MARKED [+++]](https://image.slidesharecdn.com/whitebloodcellswbc-180530054405/85/White-blood-cells-wbc-19-320.jpg)
![PROMYELOCYTES:
SIZE: 14-18uM
CYTOPLASM : INCREASED IN AMOUNT
PRESENCE OF AZUROPHIL GRANULES[PRIMARY
NON SPECIFIC GRANULES]
GIVES +VE REACTION WITH THE PEROXIDASE
STAINING
NUCLEUS: ROUND OR OVAL
SLIGHTLY SMALLER THAN MYELOBLAST NUCLEAUS
CONDENSED FINE CHROMATIN
NUCLEOLI PRESENT-LESS PROMINENT
MITOSIS: CHARACTERISTIC FEATURE{+++}](https://image.slidesharecdn.com/whitebloodcellswbc-180530054405/85/White-blood-cells-wbc-20-320.jpg)




![BAND OR STAB FORM:
ALSO CALLED JUVENILE GRANULOCYTES
SIZE: SMALLER THAN METMYELOCYTES
CYTOPLASM: PINK AND FINE EVENLY DISTRIBUTED
GRANULES
NUCLEUS: FURTHER CONDENSATION OF CHROMATIN
SHAPE:BAND CONFIGURATION [V SHAPED] OF
UNIFORM THICKNESS WHICH MAY BE TWISTED.](https://image.slidesharecdn.com/whitebloodcellswbc-180530054405/85/White-blood-cells-wbc-25-320.jpg)





















![ROLE OF CYTOKINES:
THE CYTOKINES WHICH CONTROL THE FORMATION OF DIFFERENT TYPES OF
GRANULOCYTES ARE CALLED COLONY STIMULATING FACTOR[CSF]
CSF IS A GLYCOPROTEINS FORMED BY T AND B LYMPHOCYTES
ALSO FORMS:
G-CSF: STIMULATE GRANULOCYTE PRECUSSORS
M-CSF: STIMULATE MONOCYTIC PRECUSSORS
GM-CSF: BOTH GRANULOCYTES AND MONOCYTIC PRECUSSORS
-THE CYTOKINES THAT CONTROL LYMPHOCYTE FORMATION ARE CALLED
INTERLEUKINS.
EG;IL-1,IL-3 ETC….
THE INTERLEUKINS ARE FORMED BY:
MONOCYTES MACROPHAGES
ENDOTHELIAL
CELLS](https://image.slidesharecdn.com/whitebloodcellswbc-180530054405/85/White-blood-cells-wbc-47-320.jpg)

![METABOLISM OF LEUKOCYTES:
THEY HAVE AEROBIC GLYCOLYSIS AND ACTIVE
PENTOSE PHOSPHATE PATHWAY[NADPH]
DURING PHAGOCYTOSIS OF BACTERIA,THERE IS AN
INCREASE OF O2 CONSUMPTION[RESPIRATORY
BURST] AND SUPEROXIDE RADICLE O2-[INVOLVED
IN KILLING THE BACTERIA]IS FORMED](https://image.slidesharecdn.com/whitebloodcellswbc-180530054405/85/White-blood-cells-wbc-49-320.jpg)



![NEUTROPHILS;
MORPHOLOGY:
SIZE: 10-14uM
NUCLEUS: IN YOUNG –HORSE SHOE SHAPED NUCLEUS
AS CELL GROWS:LOBED
MATURE NEUTROPHIL: PURPLE IN COLOUR
MULTI-LOBED[2-6]
THE LOBES ARE
CONNECTED BY THE CHROMATIN FILAMENTS SEEN
CLEARLY THROUGH CYTOPLASM.](https://image.slidesharecdn.com/whitebloodcellswbc-180530054405/85/White-blood-cells-wbc-53-320.jpg)






![PHAGOCYTOSIS:
PHAGOCYTOSIS [CELL EATING] REFERS TO THE PROCESS OF ENGULFMENT AND
DESTRUCTION OF SOLID PARTICULATE MATERIALS BY THE CELLS.
STEPS:
1.MARGINATION
2.EMIGRATION AND DIAPEDESIS
3.CHEMOTAXIS
4.OPSONIZATION[ATTACHMENT STAGE]
5.ENGULFMENT STAGE
6.SECREATING STAGE[DEGRANULATION]
7.KILLING OR DEGRADATION STAGE](https://image.slidesharecdn.com/whitebloodcellswbc-180530054405/85/White-blood-cells-wbc-60-320.jpg)



![COOK’S ARNETH COUNT
COUNTING THE NUMBER OF NUCLEUS WITH DIFFERENT NUCLEUS LOBES
AND EXPRESSING THE COUNT AS PERCENTAGE OF CELLS WITH
DIFFERENT NUMBERS OF NUCLEUS IS CALLED COOK’S ARNETH COUNT
USED IN JUDGING THE RATE OF FORMATION OF NEUTROPHILS
[3 LOBED CELLS ARE FULLY MATURED AND FUNCTIONALLY MOST EFFICIENT]
RIGHT SHIFT =N1+N2+N2-80% LEFT SHIFT=N4+N5-20%
INDICATES:
HIGH RATE OF FORMATION SLOW RATE OF FORMATION
MATURE
CELL
YOUNGER
CELL](https://image.slidesharecdn.com/whitebloodcellswbc-180530054405/85/White-blood-cells-wbc-64-320.jpg)
![COOK’S ARNETH COUNT:
STAGE NUCLEAR LOBES NORMAL COUNT(%)
STAGE I(N1) ONE[NUCLEUS IS C-
SHAPED]
5-10
STAGE II(N2) 2 LOBES ARE CONNECTED
BY A FILAMENT
20-30
SATGE III(N3) 3 LOBES CONNECTED BY A
CHROMATIN FILAMENT
40-50
STAGE IV(N4) 4 LOBES CONNECTED BY A
CHROMATIN FILAMENT
10-15
STAGE V(N5) 5 LOBES ARE MORE 3-5](https://image.slidesharecdn.com/whitebloodcellswbc-180530054405/85/White-blood-cells-wbc-65-320.jpg)
![EOSINOPHILS;
MORPHOLOGY:
SIZE: 10-14uM
NUCLEUS: PURPLE IN COLOUR
BILOBED 85 %
TRI-LOBED 15% [LOOKS SPECTACLE SHAPE]
CYTOPLASM:
ACIDOPHILIC AND APPEARS BRIGHT PINK IN COLOUR
COARSE DEEP RED STAINING GRANULES WHICH DO
NOT COVER THE NUCLEUS
STAINS +VE FOR PEROXIDASE
GRANULES: HISTAMINE,LYSOSOMAL ENZYME,ECF-A](https://image.slidesharecdn.com/whitebloodcellswbc-180530054405/85/White-blood-cells-wbc-66-320.jpg)



![LYMPHOCYTES;
MORPHOLOGY:
SIZE: 12-16uM ……..LARGE
7-10uM……….SMALL
NUCLEUS:
LARGE ROUND
SINGLE NUCLEUS WHICH ALMOST COMPLETELY FILL THE
CELL
STAINS:BLUE VERY DEEPLY
[INK-SPOT APPEARANCE]
NUCLEAR CHROMATIN:
CLUMPED AND SHAPELESS](https://image.slidesharecdn.com/whitebloodcellswbc-180530054405/85/White-blood-cells-wbc-70-320.jpg)


![FUNCTIONS:
B-LYMPHOCYTES
THE PLASMA CELLS
ARE RESPONSIBLE FOR
THE DEVELOPMENT OF
HUMORAL IMMUNITY
ALSO CALLED
ANTIBODIES MEDIATED
IMMUNITY[AMI]
T-LYMPHOCYTES
RESPONSIBLE FOR
THE DEVELOPMENT
OF CELLULAR
IMMUNITY,ALSO
CALLED AS,
CELL-MEDIATED
IMMUNITY[CMI] OR
T-CELL IMMUNITY](https://image.slidesharecdn.com/whitebloodcellswbc-180530054405/85/White-blood-cells-wbc-73-320.jpg)



![SUMMARY:
CELLS COMPONENTS FUNCTIONS
NUTROPHILS SPECIFIC GRANULES
MODIFIED LYSOSOMES
PHAGOCYTOSIS OF
BACTERIA
EOSINOPHILS SPECIFIC GRANULES
PHARMACOLOGICALLY
ACTIVE SUBSTANCE
DEFENCE AGAINST
PARADITES,HELMINTHS
MODULATION OF
INFLAMATORY PROCESS
BASOPHILS SPECIFIC GRANULES
CONTAINS HISTAMINS AND
HEPARIN
RELASE OF
HISTAMINS[INFLAMMATION
MEDIATORS]](https://image.slidesharecdn.com/whitebloodcellswbc-180530054405/85/White-blood-cells-wbc-77-320.jpg)
![SUMMARY:
MONOCYTES GRANULES WITH
LYSOSOMES
PHAGOCYTOSIS,AND
DIGESTION OF PROTOZOA
VIRUS ETC..
B LYMPHOCYTES IMMUNOGLOBULINS PLASMA CELL PRODUCTION
T LYMPHOCYTES CONTROL THE ACTIVITY OF
OTHER LEUKOCYTES[IL]
KILLING OF VIRUS INFECTED
CELLS
NK CELLS ATTACK VIRUS INFECTED
CELLS AND CANCER CELLS
WITHOUT PREVIOUS
STIMULATION
KILLING SOME TUMOUR AND
VIRUS INFECTED CELLS](https://image.slidesharecdn.com/whitebloodcellswbc-180530054405/85/White-blood-cells-wbc-78-320.jpg)